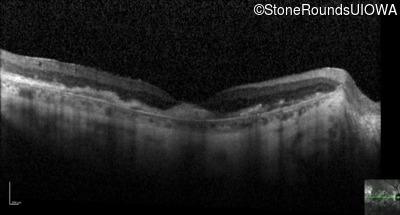
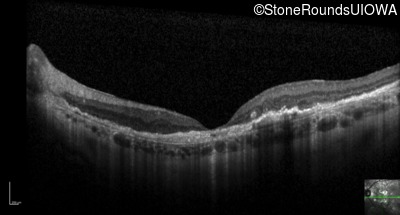
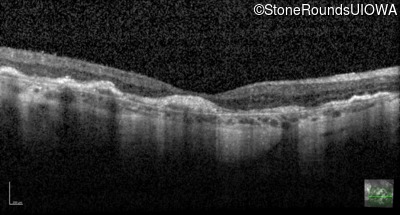
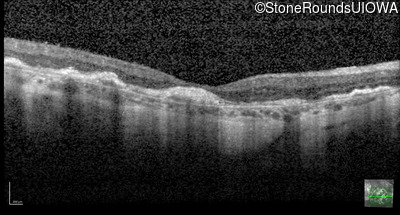
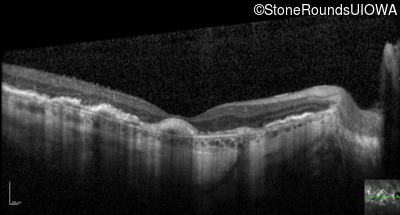
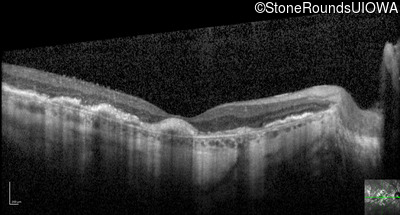
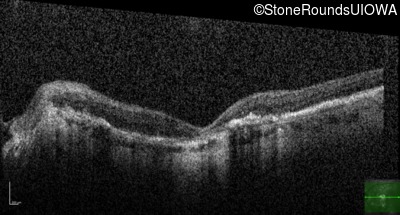
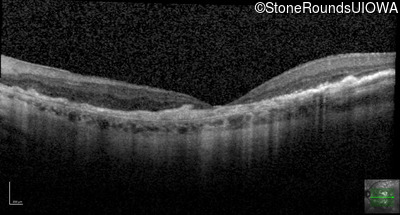
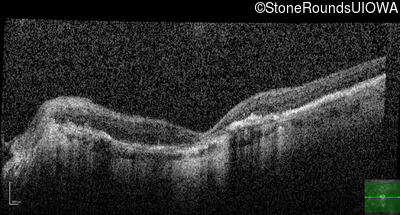
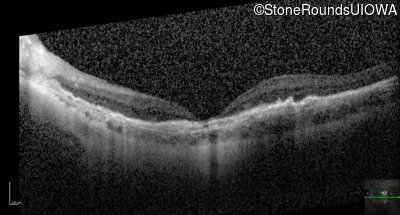
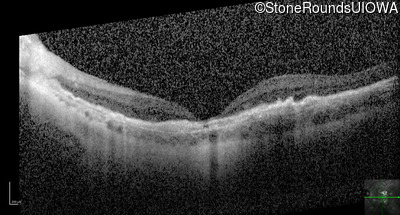
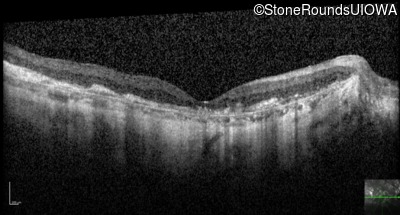
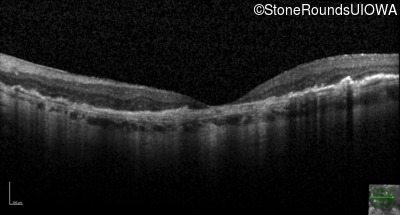
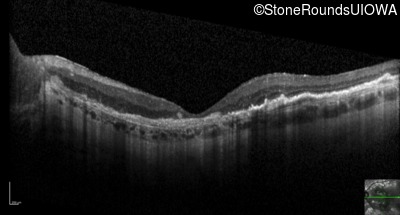
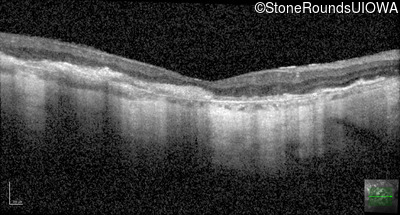
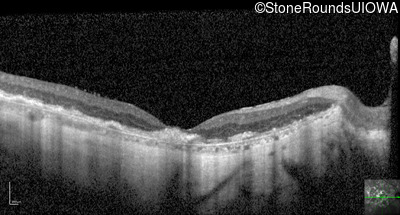
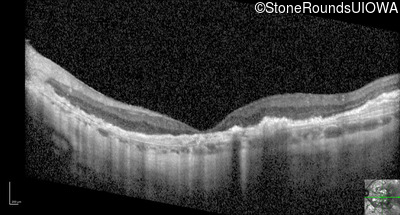

Case
SR41
Student Mode
Sorsby Fundus Dystrophy (IIH)
Female
Female
Hidden
SR41
Student Mode
Sorsby Fundus Dystrophy (IIH)
Female
Female
Visit at age: 55 years
Fundus Photography - Right - 20/125
Exemplar

Fundus Photography - Left - 20/125
Exemplar

Fundus Montage - Right - 20/125
Exemplar

Fundus Montage - Left - 20/125
Exemplar

Goldmann Visual Field - Right - 20/125
Exemplar

Goldmann Visual Field - Left - 20/125
Exemplar

Fluorescein Angiography - Right - 20/125
Exemplar

Fluorescein Angiography - Left - 20/125
Exemplar

Visit at age: 64 years
Fundus Photography - Right - 20/200 +2
Exemplar

Fundus Photography - Left - 20/160 -1
Exemplar

Fundus Montage - Right - 20/200 +2
Exemplar

Fundus Montage - Left - 20/160 -1
Exemplar

Goldmann Visual Field - Right - 20/200 +2
Exemplar

Goldmann Visual Field - Left - 20/160 -1
Exemplar

Optical Coherence Tomography - Right - 20/200 +2
Exemplar / OCT Stack

OCT Stack

Optical Coherence Tomography - Left - 20/160 -1
Exemplar / OCT Stack

OCT Stack

Infrared Fundus Photograph - Right - 20/200 +2
Exemplar

Infrared Fundus Photograph - Left - 20/160 -1
Exemplar

Visit at age: 65 years
Goldmann Visual Field - Right - 20/160 -2
Exemplar

Goldmann Visual Field - Left - 20/160 -2
Exemplar

Optical Coherence Tomography - Right - 20/160 -2
Exemplar / OCT Stack

OCT Stack

OCT Stack

OCT Stack

OCT Stack

OCT Stack

Optical Coherence Tomography - Left - 20/160 -2
Exemplar / OCT Stack

OCT Stack

OCT Stack

OCT Stack

OCT Stack

OCT Stack

Infrared Fundus Photograph - Right - 20/160 -2
Exemplar

Infrared Fundus Photograph - Left - 20/160 -2
Exemplar

Visit at age: 66 years
Goldmann Visual Field - Right - 20/160 -1
Exemplar

Goldmann Visual Field - Left - 20/125 -2
Exemplar

Optical Coherence Tomography - Right - 20/160 -1
Exemplar / OCT Stack

OCT Stack

OCT Stack

Optical Coherence Tomography - Left - 20/125 -2
Exemplar / OCT Stack

OCT Stack

OCT Stack

Infrared Fundus Photograph - Right - 20/160 -1
Exemplar

Infrared Fundus Photograph - Left - 20/125 -2
Exemplar

Visit at age: 70 years
Fundus Photography - Right - 20/160 -2
Exemplar

Fundus Photography - Left - 20/200 -1
Exemplar

Optical Coherence Tomography - Right - 20/160 -2
Exemplar / OCT Stack

OCT Stack

OCT Stack

Optical Coherence Tomography - Left - 20/200 -1
Exemplar / OCT Stack

OCT Stack

OCT Stack

Infrared Fundus Photograph - Right - 20/160 -2
Exemplar

Infrared Fundus Photograph - Left - 20/200 -1
Exemplar

Case Level Images
Diagnosis & molecular findings
Allele 1:
Ser38Cys TCC>TGC
False Genotype Rate:
Gene Count:
Submit Final Diagnosis
Clear Diagnosis